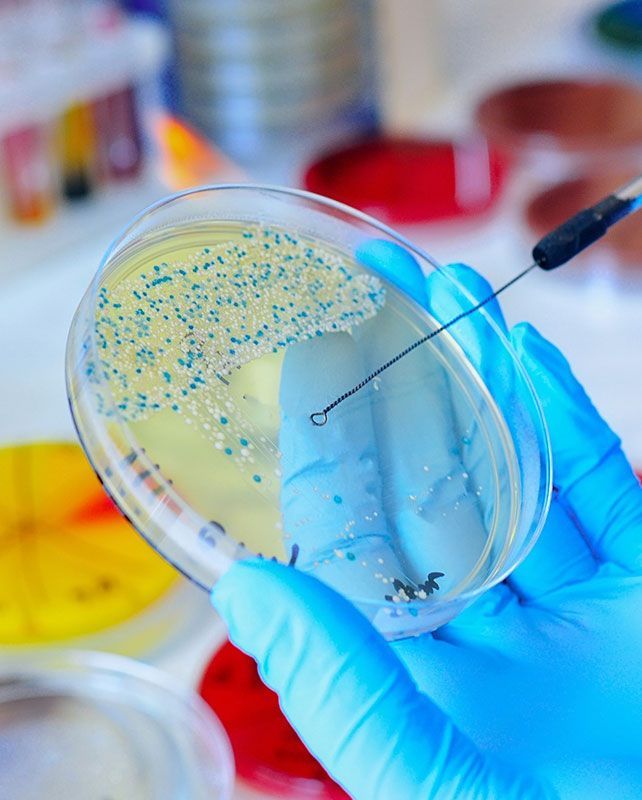
ESIANLAB S.C.

Un laboratorio de análisis de control de consumibles y cuidado personal a su servicio
Gestión de calidad con base en NMX-EC-17025-INMC-2018 (ISO-IEC 17025:2017)
En Esianlab S.C. ponemos a su disposición la más completa gama de servicios diseñados para el control de calidad de alimentos, agua y bebidas en Guadalajara, Jalisco, para que cuente con la asesoría de expertos en toma y recolección de muestras, análisis microbiológicos y fisicoquímicos para el cuidado de la salud.
Somos expertos en:
- Recolección y toma de muestras en todo el territorio nacional
- Recolección y toma de muestras las 24 horas los 365 días del año
- Análisis microbiológicos
- Análisis fisicoquímicos
- Análisis para la industria de alimentos
- Análisis y control de calidad en comedores industriales
- Ensayos microbiológicos
- Pruebas de proceso
- Pruebas de producto terminado
- Pruebas de insumos
- Pruebas de materias primas
- Pruebas de estabilidad (vida de anaquel)
- Ensayos fisicoquímicos
- Pruebas de esterilización
- Pruebas de auditorias
- Pruebas para información nutricional
En Esianlab S.C. estamos interesados en detonar el potencial de sus productos, es por ello por lo que damos resultados analíticos, confiables y oportunos.
Nuestro principal interés es apoyarle con productos de alta calidad. ¡Llámenos, le atenderemos con gusto!
MÁS DE 20 AÑOS EN EL MERCADO CUMPLIENDO SUS EXPECTATIVAS
En ESIANLAB S. C. sabemos que hay muchas cosas que debemos tomar en cuenta cuando seleccionamos un laboratorio de control de calidad, en el cual vamos a confiar nuestros productos y procesos.
La experiencia, trayectoria y servicio al cliente son factores importantes para confirmar esta decisión, pero existen otros factores que hacen la diferencia y que pueden ser más importantes a la hora de seleccionar un aliado estratégico en la confección, control y desarrollo de nuestros productos y servicios.
Estos factores son la confianza, la honestidad y la integridad. Estas cualidades son nuestra plataforma de negocios, las cuales reafirmamos continuamente y han generado que mantengamos amplias relaciones de trabajo con nuestros clientes, dándonos una permanencia de más de 20 años en el mercado, cumpliendo expectativas y tratando siempre de superarlas.
ES POR ELLO QUE TENEMOS SERVICIO PROFESIONAL EN TOMA Y RECOLECCIÓN DE MUESTRAS EN EL TERRITORIO NACIONAL EN LOS ESTADOS DE:
- Aguascalientes
- Baja California Norte
- Baja California Sur
- Campeche
- Chiapas
- Chihuahua
- Ciudad de México
- Coahuila
- Colima
- Guerrero
- Guanajuato
- Hidalgo
- Jalisco
- Michoacán
- Morelos
- Nayarit
- Nuevo León
- Oaxaca
- Puebla
- Querétaro
- Quintana Roo
- San Luis Potosí
- Sinaloa
- Sonora
- Tabasco
- Tamaulipas
- Tlaxcala
- Yucatán
- Zacatecas